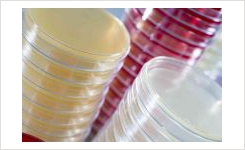

E. coli O157 (translucent), E. coli (pink/red) and sorbitol-negative E. coli (green) on Lab M Harlequin™ SMAC-BCIG. Recent cases of infection associated with the presence of E. coli O157 in a UK public park have put the organism into the news once again, especially given its potential to cause serious illness in young children.
Reliable culture and identification methods play an important role in identifying the source of outbreaks and in continued monitoring of E. coli O157, whatever the sample type, and Lab M offers a wide range of specific products for this purpose. The range includes enrichment media such as Buffered Peptone Water which is used with VCC Selective Supplement to prepare a pre-enrichment broth for organism recovery and O157 Broth MTSB (modified Tryptone Soy Broth) which serves as a selective enrichment medium for the isolation of E. coli O157.
Lab M's Captivate™ O157 immunomagnetic separation beads can reduce the time required for total viable counts, while a range of selective differential products supports the isolation of E. coli O157:H7, the primary serovar associated with haemorrhagic colitis and haemolytic uraemic syndrome. These media include Sorbitol MacConkey Agar (SMAC), which can be used with Cefixime Tellurite Supplement to prepare CT-SMAC, and chromogenic Harlequin™ SMAC-BCIG.
Harlequin™ SMAC-BCIG is a modification of SMAC agar in which the addition of a specific chromogenic substrate (5-bromo-4-chloro-3-indoxyl-ß-D-glucuronide [BCIG]) allows the improved differentiation of E. coli O157:H7 from other strains, on the basis of colony colour. The combination of Captivate™ O157 and Harlequin™ SMAC-BCIG provides a highly sensitive solution to the need for effective isolation of these bacteria from food and environmental samples.